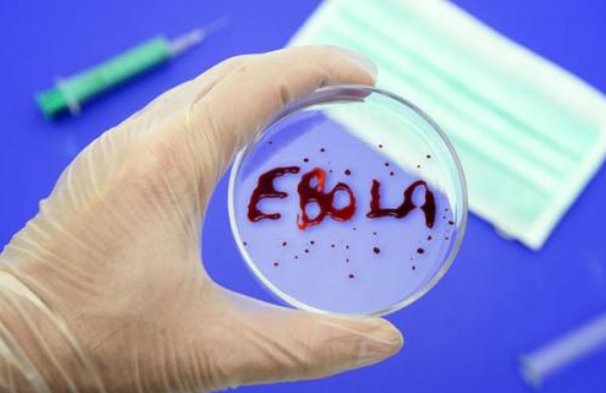
埃博拉可比新冠病毒猛太多了，为何埃博拉病毒有一个别称：内脏绞肉机？

2020年初,新冠病毒席卷了全球各地,给人们带来了巨大的恐慌,一时之间人人自危,随着新冠病毒的不断蔓延,人们对于病毒的关注度也日益提高,新冠病毒的特点就是致死率低,但是传播率高,和之前的非典型肺炎有很多相似之处,但不管是萨斯病毒还是新型冠状病毒,再有内脏绞肉机之称的埃博拉病毒面前都是弟弟。
埃博拉原本是非洲国家,刚果北部的一条河流的名字,因为这里1976年爆发了一场人间惨剧,一种不知名的病毒攻击了这里的村庄,55个村庄无一幸免,无数家庭因此而陷入巨大的灾难之中,埃博拉病毒也因此而得名,三年之后,埃博拉病毒席卷了苏丹等地,给人们带来了巨大的恐慌。埃博拉病毒又被称之为内脏绞肉机,由此就能看出埃博拉病毒到底有多可怕,大家可以到网上搜索埃博拉患者的相关图片,双眼充血,器官凹陷,同时身体还有不同程度的渗血现象,形状非常可怖,也因此,埃博拉病毒还有一个别称叫做丧尸病毒。
埃博拉病毒被称为人类有史以来最可怕的病毒,没有之一,感染埃博拉病毒的病人,在3到7天之内就会死亡,到目前为止,没有任何有效的治疗方法,也就是说,一旦感染,就只能等死,而医生所做的也只能是将病人隔离开来,避免更多的人感染。埃博拉病毒并不会直接导致人死亡,感染埃博拉病毒的人一般死于内脏感染,失血过多而产生的休克,曾经有一位医生说过,感染埃博拉病毒的病人,就相当于在你面前融化掉,病毒会攻击病人的免疫系统,让人的免疫系统全部瘫痪,同时还会出现毛细血管破裂,出血等现象,导致人的皮肤表面往外渗血,这还不是最可怕的,病毒还会攻击人体的各种系统和器官,导致各个器官出现内出血,病人的眼白也会完全变成红色,呕吐物和排泄物当中还会出现血泡,皮肤下面也会出现很多大血包,致死率在百分之50到90%之间。
埃博拉病毒之所以可怕,就是因为埃博拉病毒是直接攻击人体的免疫系统,同时还会直接导致人体内脏渗血,有一种传言说埃博拉病人甚至会偶吐出自己的内脏,当然,这属于无稽之谈,但是埃博拉病房里绝对是一副人间惨剧,病毒会在病人体内大量繁殖分解,攻击人体的器官和系统,导致器官发生病变,使器官慢慢变形,坏死,到最后被慢慢分解。这也是埃博拉病毒致死的原理,让病人器官坏死,从而终结病人的生命。我们来想象一下,感染埃博拉病毒的病人,不仅汗腺和毛孔都在往外渗血,体内的器官还在病毒作用下,慢慢被分解坏死,这是怎样一种可怖的景象!
可怕的是,对于这种病毒,我们现在还没有任何性质有效的治疗方法,更没有任何针对性的疫苗,甚至于都不知道这种病毒的起源,没有任何人知道这种病毒在每一次大爆发之后是如何潜伏下来的,也没人知道下一次爆发又是什么时候,埃博拉病毒被列为生物安全第四级病毒,也被称之为最恐怖的生化武器。而埃博拉病毒不仅能够感染人体,而且还能够感染动物,它感染人体的原理和很多病毒一样,是通过体液传播。接触感染者的体液,汗液,血液等分泌物,就有可能被感染。
自1976年,出现埃博拉病毒之后,每次埃博拉病毒的出现,都牵动着人们的心,截至2014年,全球累计的埃博拉病毒人数已经高达15351,2014年到2016年,非洲西部再次爆发大规模的埃博拉病毒,这次爆发直接导致13000人死亡,可是这并不意味着埃博拉病毒的结束,从2016年开始,埃博拉病毒还在世界各地持续不断的肆虐,2020年埃博拉病毒还通过飞机传到了北美南亚等地,可以这样说,埃博拉病毒死神的翅膀已经开始张开。
值得庆幸的是,埃博拉病毒暂时还不会传到中国,可是人类是命运共同体,埃博拉病毒应该是全人类的共同敌人,希望人类能够早日战胜埃博拉病毒。



